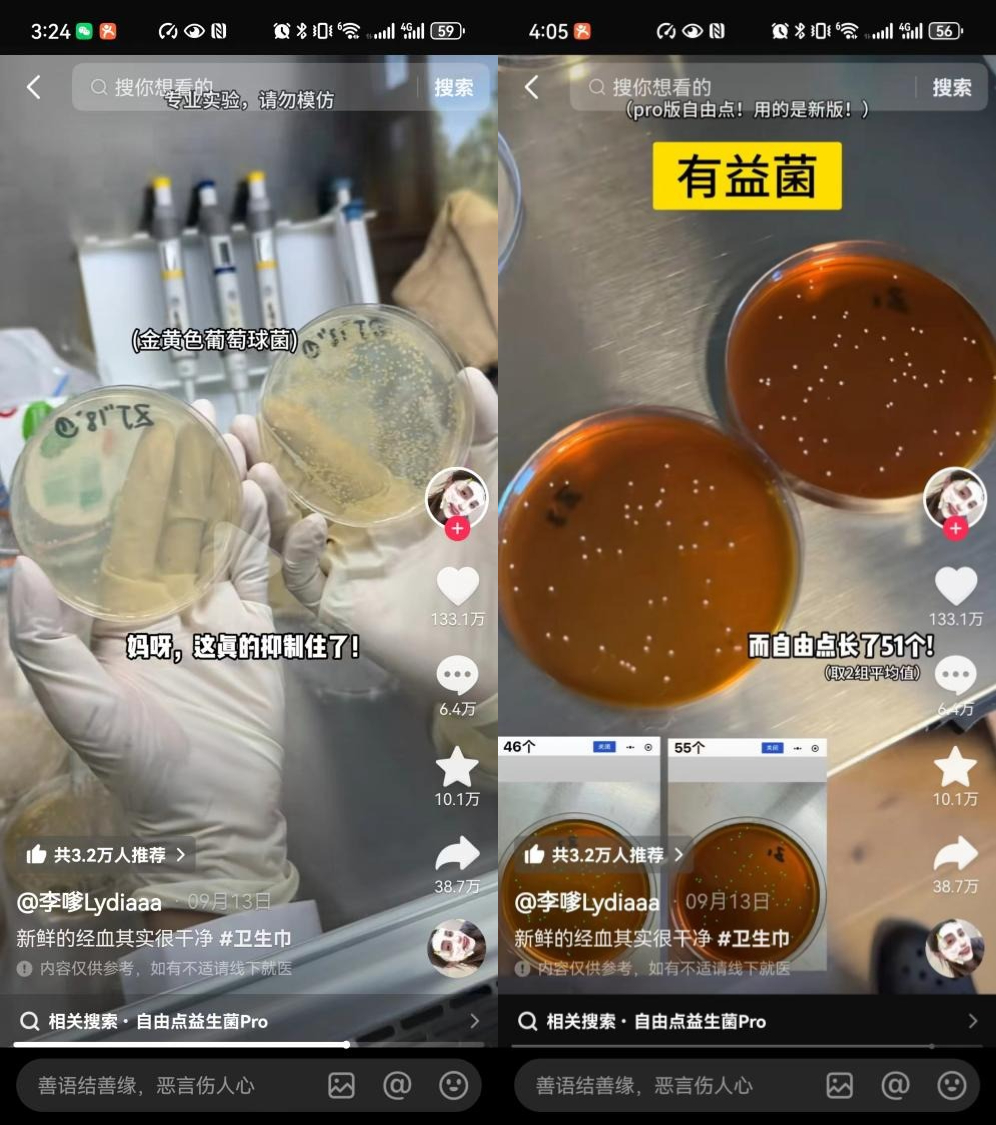
1727404712717067859.jpg

抑制有害菌促生有益菌 这款卫生巾究竟有多厉害?
“原来真的有卫生巾可以抑制有害菌,促生有益菌!”近日,百万级粉丝博主李嗲和北大学霸付铁寒发布的实验视频被网友评为“全网最硬核的卫生巾测评”,引发行业内外高度关注。实验以超强可视化效果实证自由点益生菌PRO可以有效抑制有害菌,促生有益菌,网友惊呼:“自由点卫生巾卷到可怕!”
实验室硬核评测 抑菌、促菌有理有据
根据视频显示,学霸博主付铁寒从实验室的维度上对自由点益生菌产品的抑菌效果进行了对照实验。首先选用阴道常见有害菌种在实验室中进行培养:白色念珠菌、金黄色葡萄球菌、大肠杆菌,然后分别用自由点卫生巾产品面层、无菌纱布对菌液进行处理。经过18h振荡和48h培养后观察,实验组(用自由点益生菌pro卫生巾处理的菌液培养皿)的有害菌落总数明显低于空白组(什么都没放的菌液培养皿)和对照组(用无菌纱布处理的菌液培养皿)。经数据统计,自由点对3种有害菌的抑制作用都达到国家标准的要求。
对于李嗲提出的“会不会把有益菌也杀死了”的疑问,付铁寒又进行了一轮有益菌促生实验。将含有阴道有益菌的菌液用自由点益生菌PRO产品面层进行处理,振荡18h后放入培养皿培养。实验结果显示,相比空白对照组与无菌纱布对照组,自由点益生菌PRO是真的有促进有益菌生长的作用。
实验结束后,学霸博主付铁寒表示:“它真的能促进益生菌生长,而抑制有害菌,异味就会小很多”,不过学霸也表示“卫生巾真的太卷了。”
新型专利发明 经期健康新选择
抑制有害菌促生有益菌,这款卫生巾凭什么这么厉害?我们知道,女性在月经期间,体内雌激素、孕激素水平下降,同时偏碱性的经血冲刷都会造成阴道菌群多样性增加及阴道微生态环境稳定性下降。
自由点益生菌PRO卫生巾添加了灭活益生菌及其代谢产物:女性专利益生菌嗜酸乳杆菌LA88+植物乳杆菌N13+益生元,其作用是促生人体自身的有益菌,而非外源性补充。通过在使用过程中释放益生菌,促生有益菌的同时减少阴道有害菌的繁殖,为女性经期提供持续的保护,更好地实现经期私处健康。

据了解,该产品通过菌群改善人体功效实验、阴道黏膜测试、皮肤变态反应、皮肤0敏感测试等11项第三方检测、实验机构认证。根据体外试验和人体实验证据表明:自由点益生菌PRO卫生巾可以有效促进阴道有益乳杆菌生长,有助于改善阴道菌群多样性、降低阴道致病菌的相对丰度、提高阴道有益菌相对丰度,从而发挥阴道微生态调节作用。
目前,自由点益生菌PRO卫生巾已经上市,相信这样一款“科学”加持、引领行业革新的卫生巾,能够为女性带去更舒适更健康的经期体验。
免责声明:本网站有部分内容均转载自其它媒体,转载目的在于传递更多信息,并不代表本网赞同其观点和对其真实性负责,若因作品内容、知识产权、版权和其他问题,请及时提供相关证明等材料并与我们联系,本网站将在规定时间内给予删除等相关处理.
猜你喜欢






